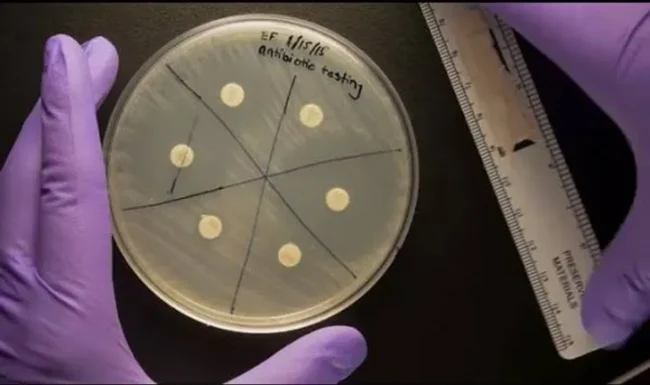
Antibiyotik Duyarlılık Testi

Son Haberler ve Makaleler (1)

Temiz Gıdaya Erişim, İnsan Hakları ve Halk Sağlığı Krizi!
Sağlık çoğu zaman sadece “kişisel tercihler” gibi sunulur: “Yürürsen iyi olursun, sebze yersen sorun çözülür.” Evet, bunlar doğru ama eksik. Asıl sorun görünenin arkasında gizli: Sağlık Politikaları, İnsan Hakları ve…
Arşivdeki Makaleler (8)

Sağlık Diplomasisi ve Küresel Sağlık Güvenliği
Sağlık Diplomasisi ve Uluslararası İlişkiler: İşbirliği ve Rekabetin Karmaşık Dinamikleri Küreselleşen dünyada, sağlık artık sadece ulusal bir mesele değil, uluslararası güvenlik ve istikrarın temel bir unsuru haline…

Sağlık Gerçekleri: Sahte Haberlerin Anatomisi, Dezenformasyon ve Manipülasyon
Sahte Haberlerin Anatomisi, Dezenformasyon ve Manipülasyon Sağlık, her zaman hassas bir konu olmuştur. Sağlığımızla ilgili doğru bilgiye ulaşmak, bilinçli kararlar almak ve kendimizi korumak için hayati önem taşır.

Sağlık Teknolojilerinde Yeni Ufuklar Açmak!
Türkiye Sağlık Vakfı Projeleri: Sağlık Teknolojilerinde Yeni Ufuklar Açmak! Türkiye Sağlık Vakfı (TSV), sağlık teknolojilerinde ilerlemeyi ve inovasyonu teşvik ederek, Türkiye'nin sağlık alanında geleceğe hazır olmasını…

“Türkiye Sağlık Vakfı” Doktorların Sesi Olacak!
Birey ve toplum sağlığına yönelik projeler üreterek yaşam boyu sağlık eğitimlerini destekleyen Türkiye Sağlık Vakfı, sağlık sektöründe önemli bir adım atarak yeni bir girişim başlattı. Bu yeni girişim ile Türkiye…
Antibiyotik Duyarlılık Testi
Antibiyotikler, bakteriyel enfeksiyonlarla savaşmak için kullanılan ilaçlardır. Farklı antibiyotik türleri vardır.

Kolajen takviyesi yaygınlaşıyor.
34-45 yaş grubundaki kadınların yüzde 12'si düzenli bir şekilde kolajen ürünü kullanıyor. Her 100 kadından 34'ü mutlaka ürünün içeriğini inceliyor.
 DSÖ (WHO)
DSÖ (WHO)  GTÖ (FAO)
GTÖ (FAO)  UNEP
UNEP  DHSÖ (WOAH)
DHSÖ (WOAH) 


